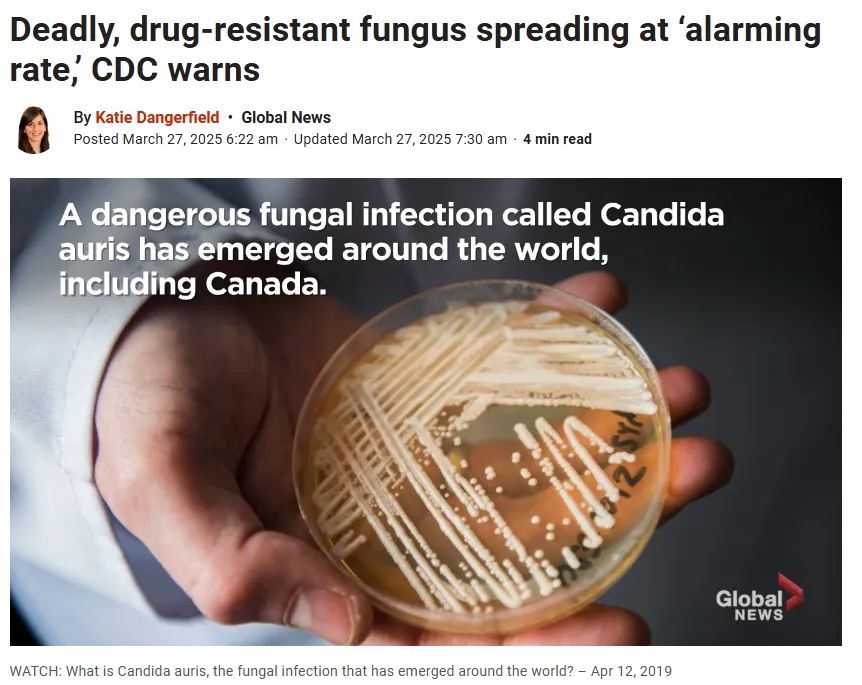

-
日期: 2025-04-01 | 來源: 加拿大家園 | 有0人參與評論 | 字體: 小 中 大
壹種叫 耳念珠菌(Candida auris,簡稱C. auris) 的“超級真菌”正在美國的醫院和療養院快速蔓延,美國疾病控制與預防中心(CDC)警告,這種真菌很難殺死,對多種藥物免疫,並將其列為“緊急公共衛生威脅”。
CDC表示,這種真菌不僅耐藥性強,還能在醫療機構中快速傳播,導致高死亡率的嚴重感染。
加拿大也出現病例,官方開始重點監測。C. auris 最早於2009年在日本被發現,隨後在全球各地的醫院和護理機構爆發多次疫情,加拿大也中招了。
今年1月,安大略省公共衛生局 把 C. auris 列為“重點監測疾病”,也就是說,官方已經意識到它的危險性,並要求加強監測和防控。
死亡率高達50%-60%,免疫力弱的人最危險!加拿大微生物學家 Jason Tetro 解釋說,C. auris 本來只是寄生在皮膚上的酵母菌,對健康人沒什麼影響。
但如果它進入血液或黏膜,就可能引發嚴重感染,甚至致命!
Tetro 透露,這種真菌的死亡率最高可達60%,尤其是免疫力較弱的人群,比如老年人、糖尿病患者和癌症患者,感染後風險更高。
更糟糕的是,即使患者被治愈,他們可能仍會長期攜帶 C. auris,並無意中傳染給別人。
普通消毒劑無效,它能在物品表面存活數周這種真菌的傳播能力相當強,不僅可以人與人之間傳播,還能在物體表面存活數周,比如:
病床欄杆
門把手
醫療設備
更麻煩的是,普通清潔劑根本殺不死它!- 新聞來源於其它媒體,內容不代表本站立場!
-
原文鏈接
原文鏈接:
目前還沒有人發表評論, 大家都在期待您的高見